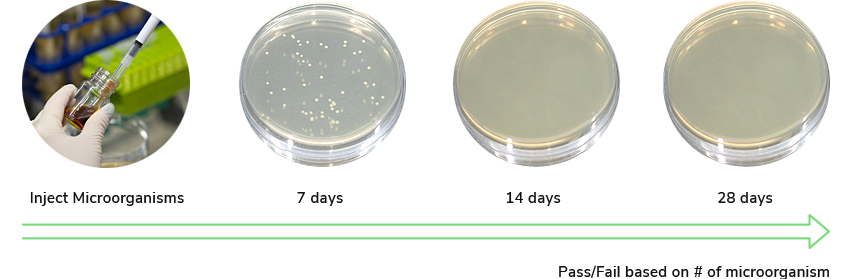

Complies with national testing guidelines: ISO 11930, CTFA, USP 51, etc.

Reject E-mail collecting
The Cosmax website prevents and does not allow any act or attempt to collect e-mail addresses present in this website by programs for collecting e-mail addresses or by other technical means without our prior approval. Be advised that any violation of this provision may result in criminal penalties in accordance with the Information Network Act.